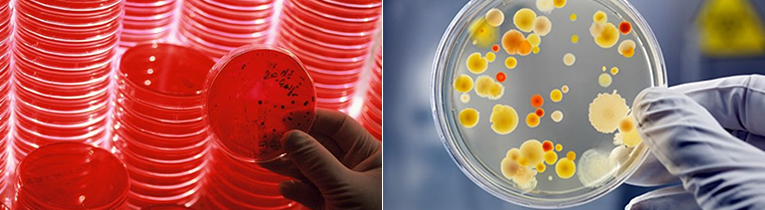

검사안내
검사안내
혈액(진공(SST)) Tube에 채혈하는 경우
검사항목에 필요한 양 만큼의 혈액을 뚜껑을 열 필요없이 진공(SST) 상태로 채취합니다.
일반 주사기로 채혈하는 경우

검사항목에 필요한 혈청량의 2~3배 이상을 채혈하여 주사기 끝을 튜브의 기벽에 대고 살며시 넣어 주십시오. 심하게 주입하는 경우 용혈이 발생하므로 주의하시기 바랍니다.
채취한 혈액을 잘 혼합하여 안정한 후 20~30분이 경과하면 2,500~3,000rpm에서 3~4분 정도 원심분리 하십시오. 분리된 혈청은 다른 용기에 옮길 필요없이 그대로 보관 하십시오.
혈청분리관(Seperator)에 혈청을 분리한 경우에는 혈청분리관 입구를 새지 않도록 완전히 밀봉한 후 보내주시기 바랍니다.
일반 혈액 검사(CBC)
EDTA 진공 튜브에 혈액 3mL를 채혈한 후 즉시 튜브를 위아래로 10회 정도 전도혼합 한 후 2시간 이내에 검사가 진행 되어야 하며 실온에서 6시간 이상 방치하면 MCV, ESR, PLT, WBC Count, Reticulocyte의 결과(2일내 소실) 등에 영향을 미칠 수 있으므로 즉시 검사가 어려울 경우에는 4˚C에서 냉장 보관 하시기 바랍니다.
혈액도말 및 골수검사 (혈구관찰을 목적으로 하는 검사 ; Blood Smear 등)
신선한 검체를 사용하여 유리슬라이드 위에 얇고 고르게 퍼진 도말 표본을 만들어야 합니다. 정확한 도말표본 판독을 위해서는 일반 혈액검사(CBC) 결과가 필요하므로, 반드시 소견을 제공하여 주십시오. 말초혈액 도말 판독(Peripheral blood smear, PBS) lancet 천자로 혈액을 얻어 도말을 만드는 것이 좋습니다.
혈액응고 검사
혈액응고 검사는 Sodium citrate 진공 튜브에 채혈된 혈액을 사용하며 혈액과 항응고제의 비율은 9:1 입니다. 채혈량을 정확히 지켜 주시기 바랍니다. 비율이 정확하지 않을 경우 검사결과가 달라질 수 있으며 육안적으로 용혈 검체나 지방성분이 많아 혈장이 혼탁하거나 응고된 검체 등은 혈액응고 검사 결과에 부적절하므로 혈액을 재 채취하여 검사 하는 것이 바람직합니다.
세포면역 검사(Lymphocyte subset)
CBC검사용 EDTA 튜브에 혈액 3mL을 채혈합니다. 이때 검체는 반드시 실온상태로 보관하여 주시고 검체의 안전성을 위하여 주말 및 휴일 전일 의뢰는 삼가하여 주시기 바랍니다.
부적합 검체
검체량이 부족하거나 심하게 용혈된 검체
응고된 검체
EDTA 또는 Heparinized whole blood 이외의 항응고제를 사용한 검체
냉장 보관하였거나 실온에서 24시간 이상 경과된 검체

1. 단회 뇨(Random urine)
채취시간
① 아침 첫 소변(특히 임신반응 검사)이 농축되어 있으므로 일반적인 검사에 가장 적합합니다.
② 반드시 식후 2시간 이상 경과하고 심한 운동을 하지 않은 때에 채취 하십시오.
보관방법
의뢰하기 전까지 반드시 냉장 보관 하십시오.
채취방법
요 검사를 위한 채뇨 법으로는 중간 뇨(Midstream voided urine)가 가장 적합합니다.
남자는 포피가 없는 자는 그대로, 포피가 있는 자는 음경 귀두를 노출시켜 힘차게 배뇨시켜 앞의 반은 버리고 후반의 뇨를 채뇨 하십시오.
정확한 뇨검사를 위하여 성인 여자의 채뇨는 신중을 기하여야 합니다.
질, 외음부에서 유래한 성분의 혼입을 절대로 피하기 위하여 외음부 주위를 깨끗이 세척하여 중간 뇨를 취합니다.
월경시나 질 분비물이 많은 경우 검사자에게 뇨 상태를 알려주어야 합니다.
2. 24시간 뇨 (24hr's urine/day)
주의사항
24시간 뇨를 받을 때는 알코올이나 기타 영향을 미칠 수 있는 음식 또는 약물 복용을 금합니다 .
모든 정량적인 검사는 24시간 뇨를 채취하여 그 양을 정확히 측정하고, 잘 혼합한 후 적당량을 추출한 후 보냅니다 . (반드시 총 뇨량을 기록하여 주십시오.)
검사항목에 따라 보관방법, 보존제 첨가 등을 확인 하시기 바랍니다.
채취방법
채뇨를 시작할 때는 일단 방광을 완전히 비우도록 배뇨시키고, 이때 뇨는 버리십시오.
이로부터 24시간 내의 뇨를 전부 모으십시오.
( 예 : 오전 6시부터 그 다음날 오전 6시까지의 뇨를 모으고자 할 경우는, 첫날의 6시 첫 뇨는 버리고 다음 뇨 부터 다음날 6시까지 전부 채취합니다.)
( 예 : 오전 6시부터 그 다음날 오전 6시까지의 뇨를 모으고자 할 경우는, 첫날의 6시 첫 뇨는 버리고 다음 뇨 부터 다음날 6시까지 전부 채취합니다.)
24시간 Urine 보존제 안내
| 검사항목 | 무 방부제 |
6N HCI |
비고 | 보존조건 | 검사항목 | 무 방부제 |
6N HCI |
비고 | 보존조건 |
|---|---|---|---|---|---|---|---|---|---|
| 17-ketosteroids | - | - | 1% HCI | 냉장 | Cyclic AMP(cAMP)Cyclic | - | - | Toluene | 냉장 |
| 17-OHCS | - | - | 1% HCI | 냉장 | HVA(Homovanillic Acid) | - | ● | - | 냉장 |
| 5-HIAA | - | ● | - | 냉장 | Hydroxyprolime, free | - | ● | - | 냉장 |
| Aldosterone | - | - | Boric acid | 냉장 | Hydroxyproline, total | - | ● | - | 냉장 |
| Arsenic | ● | - | - | 냉장 | Mg (Magnesium) | ● | - | - | 냉장 |
| BUN | ● | - | - | 냉장 | Metanephrine | - | ● | - | 냉장 |
| Cadmium (Cd) | ● | - | - | 냉장 | Microalbumin | ● | - | - | 냉장 |
| Calcium (Ca) | - | ● | - | 냉장 | Oxalate | - | ● | - | 냉장 |
| Catecholamine | - | ● | - | 냉장 | Porphobilinogen | - | - | 10% Sod, Carbonate |
차광/냉장 |
| Citrate | - | ● | - | 냉장 | Pregnanetriol | ● | - | - | 냉장 |
| Cobalt | ● | - | - | 냉장 | Protein EP | ● | - | - | 냉장 |
| Copper | ● | - | - | 냉장 | Protein, Total | ● | - | - | 냉장 |
| Coproporphyrin | - | - | 10% Sod, Carbonate |
차광/냉장 | Uric acid | ● | - | - | 냉장 |
| Corticol | ● | - | - | 냉장 | VMA | - | ● | - | 냉장 |
| Creatine | ● | - | - | 냉장 | ZN (Zinc) | ● | - | - | 냉장 |
| Creatinine | ● | - | - | 냉장 | δ-ALA | - | ● | or 50% acetic acid |
차광/냉장 |
미생물 검사 의뢰 시 주의사항
정확한 감염 부위에서 적절한 시기에 채취해야 합니다.
모든 검체는 지정된 멸균 용기에 채취하고 Stool 이외의 검체는 무균조작으로 채취되어야 하며 면봉, 시험관, 수송배지, Blood culture 배지 등은 사용 전에 오염 여부나 유효기간을 확인한 후 사용합니다. 모든 미생물 검체는 안전하게 취급하기 위해서 외부에 노출되지 않도록 꼭 맞는 뚜껑이 있는 용기에 채취합니다. (Blood culture배지, 수송배지는 실온에 보관하며 수송배지로 검체를 보낼 때는 반드시 2개의 면봉 모두에 검체를 잘 묻혀서 건조되지 않도록 배지에 깊이 찔러 넣어 보냅니다.)
임상 소견, 검체 종류 및 채취 부위와 시간, 항생제 투여 여부를 기재하여야 하며 검체 채취는 통상적으로 항생제 투여 전에 합니다. (기재된 정보에 따라 1차 접종배지의 종류, 배양조건, 동정을 요하는 균의 종류 등이 달라질 수 있으므로 반드시 기재합니다.) 의뢰된 검체는 환자확인이 가능한 사항(환자명, 생년월일, 병원명 등)이 기록되어 있어야 합니다.
채취된 검체는 즉시 검사실로 보내어 검사하여야 하며(특히 뇌척수액 검체, 창상배양 검체 등) 지연되는 경우 검체별 보관조건을 지켜 가능한 빨리 검사실로 운송합니다.
수송배지를 즉시 배양할 수 없을 때는 냉장 보관하여 운송합니다. 단, 수막구균이나 임균 등의 Neisseria 균속이나 Hemophilus 균속이 의심되는 검체는 30℃ 이하로 내려가면 사멸하므로 실온이나 37℃에 보관하며, 혈액검체 및 뇌척수액도 반드시 실온보관 합니다.
바이러스 배양검사

바이러스 배양법은 원인 바이러스가 자랄수 있는 세포를 사용하므로, 검체 또한 감염 병소에서 채취해야 합니다.
일반적으로 질병 경과가 갈수록 바이러스 검출율은 낮아지므로, 바이러스 농도가 높은 감염초기(급성기)에 채취하는 것이 좋습니다.
주로 이용하는 검체는 체액, 삼출액, 조직, 상기도 세척액, 대변 등입니다.
바이러스 운송용 배지는 안내서에 권유한 내용대로 사용하시고, 운송배지는 세균의 증식을 억제하는 성분이 함유되어 있습니다.
검체는 바이러스 운송용 배지에 넣어 4℃에서 가능한 빨리 검사실로 보내져야 하며, 즉시 실험하여야 하나 만약 그렇지 못한 경우에는 3~4일 이내에 접종이 이루어져야 하며, 장기간 보관시는 -70℃에 냉동 보관합니다.
검체 채취시기
건강한 신생아의 경우 가장 이상적인 채혈 시기는 생후 48-72시간 사이로, 일반적으로 퇴원 전 채혈하는 것이 좋습니다. (생후 특정 아미노산의 혈중 증가율은 질환의 심각성이나 단백질 섭취량에 따라 달라지므로 너무 일찍 검사를 실시하는 경우 위음성을, 반대로 정상 신생아에서 출생 직후 TSH surge가 있으므로 48시간 이전에 채취한 검체에서는 갑상선 기능 저하증에 대한 위양성의 결과를 초래할 수 있습니다.)
입원 기간이 연장되는 미숙아 등에서는 생후 7일 정도에 검체를 채취하는 것이 좋으며 입원일이 14일을 초과하는 경우는 퇴원시, 1개월 이상일 경우는 1개월 째 재검을 실시함이 바람직합니다.
수혈이 필요한 경우는 가능하면 수혈 받기 전에 초기 검체를 채취하도록 하며, 수혈 전 채취한 검체가 생후 24시간 이내 채취되었을 경우 생후 30~60일에 재검을 실시하는 것이 좋습니다. 또한 채혈 Card에 수혈 후 검체를 채취하였다는 내용과 함께 가장 최근 수혈한 날짜를 반드시 기입하여 주시기 바랍니다.
검체 채취요령(여과지에 채혈)
신생아 발뒤꿈치의 모세 혈관에서 여과지를 이용하여 다음 순서에 따라 혈액 검체를 채취하십시오.

먼저 수검자를 확인합니다. 담당 진료의로부터 검사 의뢰서(검사 항목 Check)가 전달되면 수검자의 확인을 위해 식별표 (신생아의 손목 또는 발목에 착용)와 검사 의뢰서의 수검자 정보가 일치하는지 확인하며 채혈지에 기록사항을 정확하게 빠짐없이 기록합니다.
장갑을 착용합니다.
발에 혈류를 증가시키기 위해 환아의 다리를 심장보다 아래쪽에 위치하도록 합니다.
발뒤꿈치를 따뜻하게 합니다. (3분 정도 따뜻한 물수건으로 뒤꿈치를 감싸면 혈류를 증가시킬 수 있습니다.)
오염을 방지하기 위하여 검체를 채취하는 동안 Filter paper에 그려진 원을 절대로 손으로 만져서는 안됩니다. 또한 Filter paper가 물이나 알코올, 방부제, 로션, 파우더 등에 닿지 않도록 주의해야 합니다.
채혈 부위를 70% isopropanol로 닦습니다. 남아있는 알코올을 마른 Dry sterile gauze로 닦아낸 후 마르도록 기다립니다. (베타딘 소독시 TSH 위양성을 보일 수 있으므로 사용을 금합니다.)
신생아의 발뒤꿈치 바닥에 소독한 일회용 lancet(2.4 mm point 이하)을 이용하여 재빨리 깨끗한 Puncture를 합니다.
소독된 Gauze pad로 처음 나온 혈액 한 방울을 닦아낸 후 커다란 방울이 되도록 합니다.
Filter paper를 커다란 혈액 방울에 대어서 충분한 양의 혈액이 한번에 Filter paper에 그려진 원을 채워 흡수되도록 합니다.
채혈 후 발을 몸보다 위에 위치하도록 하고, 피가 멈출 때까지 채혈 부위를 소독한 거즈나 솜으로 꼭 눌러주 십시오.
주의사항
Paper를 채혈부위에 대고 눌러서는 안 되며, 채혈부위를 쥐어짜서도 안 됩니다.
혈액을 Filter paper의 한쪽 면에 만 묻히도록 합니다.
계속해서 나오는 혈액 방울을 동일한 원 안에 다시 묻혀서는 안되며, 혈류가 감소하여 원이 완전히 채워지지 않았으면 새로운 원에 채혈을 다시 합니다.
이러한 과정을 반복하여 Filter paper에 있는 네 개의 원을 완전히 채우십시오.
Capillary튜브를 사용하지 마십시오.
혈액여지는 오염물질이 없는 평평한 곳에서 실온 상태로 3~4시간 정도를 충분히 건조합니다.
열이나 직사광선에 직접적으로 노출되지 않게 주의하여 주십시오.
운송 시 주의점
채혈지가 완전히 건조되기 전에는 봉투 속에 넣지 말아 주십시오.
환자 정보가 빠짐없이 기재되었는지 확인하여 주십시오. (17-OHP의 경우 반드시 출생 시 체중을 기입하여 주십시오.)
검체가 완전히 마른 후 모아놓거나 방치하지 말고 가능한 한 채취 후 24시간 안에 검사실에 보내 주십시오.
말초혈액(Peripheral blood ; PB) 검체
Sodium heparin 튜브에 혈액 5mL(소아 3mL)을 무균적으로 채취하여 전도혼합 한 후 응고되지 않도록 합니다.
주의사항
Sodium heparin 이외의 항응고제는 세포 분열능 저하로 인하여 배양에 실패할 확률이 높습니다.
환자의 임상소견 및 추정 진단에 따라 검사 방법 자체가 달라지므로 반드시 의뢰서에 기록합니다.
검체 채취부터 배양까지 24시간 이상이 경과되면 검사에 실패할 확률이 높습니다.
검체 보관 및 운송은 실온 상태로 합니다.
태아조직(Products of conceptus ; POC) 검체
태아 조직은 오염될 확률이 매우 높으므로 무균적으로 채취하여야 하며 전용용기에 넣어 의뢰 하시기 바랍니다.
주의사항
자궁 내에서 사망한지 24시간 이상이 경과한 검체는 배양에 실패할 확률이 높습니다.
양수(Amniotic fluid ; AF) 검체
검체에 모체 세포가 혼입되는 것을 방지하기 위해 채취시 처음 약 2mL 정도를 반드시 버린 다음 20~30mL 정도의 양수를 무균적으로
채취하고 이를 15mL Conical 튜브 2 Bottle로 옮겨 의뢰하시기 바랍니다.
주의사항
양수 내 태아 유래 세포가 적은 경우(원심 후 침전물이 육안으로 확인이 안됨)와 육안적으로 검체의 색깔이 붉거나(혈액이
혼입되었음을 의미) 짙은 갈색인 경우는 배양에 실패할 수도 있습니다.
융모막(Chorionic villi sampling ; CVS) 검체
융모막 20~40mg을 채취하여 융모막 전용용기에 넣어 의뢰하시기 바랍니다.
주의사항
Zoom-stereo microscope으로 관찰하여 순수한 융모막이 적을 경우에는 직접법, 배양법을 병행할 수 없고, 단지 배양법만을 시행함 으로 모체 세포의 오염 가능성이 높아집니다. 그리고 검체량 부족으로 인하여 결과가 지연되거나 혹은 배양에 실패할수 도 있습니다.
제대혈(Cord blood) 검체
제대혈은 응고가 잘 되므로 채취 후 즉시 Sodium heparin 튜브에 넣고 전도혼합 하여 응고가 되지 않도록 주의하시기 바랍니다.

세포병리 검체 채취 시 주의사항
세포 검사용 검체는 세포 변성을 방지하여 정확한 세포 관찰을 할 수 있도록 95% Ethylalcohol 또는 Cytospray등 피복 고정제(Coating fixation)로 반드시 고정하십시오.
95% 에탄올(Ethyl alcohol)로 고정하는 경우 적어도 30분 이상 고정하여야 합니다.
피복고정제(Coating fixation)는 도말된 슬라이드로 부터 25~30cm거리를 둔 위치에서 분무합니다.
검체별 도말표본 제작방법
부인과 세포검사(Gy cytology)
채취 부위 : 자궁 질부(Portion), 자궁 경부(Cervix), 자궁내막(Endometrium)
검체 채취 시 기구나 장갑에 윤활제 또는 Talcum powder를 사용하지 않고 수분이 필요한 경우는 Warm saline을 사용합니다.
검체는 한 번에 많이 채취한 후 Slide에 얇고 균일하게 도말하고, 세포 고정제를 분무합니다.
검체 채취 하루 전에 질 내 치료나 피임약제 등의 사용을 하지 않습니다.
Pap brush나 Cyto brush로 검체를 채취할 경우 심한 출혈이 발생하지 않도록 주의합니다. (과도한 혈액 혼입은 진단에 방해를 줄 수 있습니다.)
액상세포용기를 사용하는 경우 Cyto brush로 채취한 모든 세포를 액상용기 안의 액체에 풀어 넣은 다음 새지 않게 뚜껑을 잘 밀봉하여 보냅니다.
객담(Sputum)
아침 첫 객담을 받아 병적(변색, 짙은 갈색, 혈액 등) 부분을 두 장의 Slide 사이에 넣고, 전후좌우로 비벼 펼친 다음 즉시 95% 에탄올에 고정합니다.
채취 시 타액이 섞이지 않도록 주의하고 객담 자체를 의뢰하실 경우 냉장 보관하여 24시간 이내에 의뢰하시기 바랍니다.
요, 뇌척수액(Urine, CSF)
1,500rpm에서 10분간 원심분리하여 침전물을 Slide에 도말한 후 고정합니다.
원심분리가 불가능 할 경우 검체에 50% 에탄올을 검체의 양과 같은 양으로 혼합하여 보냅니다.
체액(Fluid (other))
흉수액(Pleural fluid), 복수액(Ascitic fluid) 등
가능한 전량을 혼합하여 원심한 후 Egg albumin을 침사에 첨가하여 Slide에 도말하고, 즉시 95% 에탄올로 고정합니다.
도말이 불가능할 때는 검체를 냉장 보관하여 24시간 이내에 의뢰하시기 바랍니다.
천자액(Aspiration biopsy)
유선, 갑상선, 림프액 등
2~4장의 Slide에 도말한 후 일부는 즉시 고정하고, 일부는 자연 건조하여 고정합니다.
검체량이 적은 경우는 주사바늘과 주사통을 생리식염수로 세정하고 원심분리하여 침전물로 도말한 후 고정합니다.
pH가 낮은 검체
위액, 담즙 등
검체는 얼음을 채운 Box에 보관하고, 가능하면 즉시 원심분리하여 도말 Slide를 만들어 고정합니다.
고정이 불가능할 때에는 70% 에탄올을 검체의 1/3~1/4 정도의 양이 되도록 넣은 후, 얼음 Box에 넣어 의뢰하시기 바랍니다.
조직병리 검체 채취 시 주의사항

수술 조직을 새지않게 용기에 옮긴 후 고정액으로 10% 중성 포르말린(Formalin)을 넣어 조직이 완전히 잠기게 하십시오. 포르말린 고정액은 조직의 약 10배 정도의 양으로 넣으십시오.
포르말린을 사용하는 목적은 적출한 조직의 자가융해 및 건조를 방지하기 위한 것이며, 검체 보존성이 뛰어납니다.
만약 부위가 다른 곳에서 적출한 조직이라면 각각 다른 용기에 넣고 고정하십시오.
Punch biopsy등 작은 생검 조직은 거즈나 여과지에 붙여 유실되지 않도록 처치한 후 고정하십시오.
검체별 고정방법
자궁 등 큰 장기
용기의 절단면을 아래로 하여 넣고, 고정액을 충분히 넣어 잠기도록 합니다.
소화관 등 점막 장기
점막 부위를 밖으로 뒤집어 얇은 거즈로 잘 싸서 고정합니다.
폐(Lung)
기관지 말단으로부터 고정액을 주입하여, 가능한 폐포를 부풀려 공기를 빼고 조직 사이까지 골고루 고정액이 들어가도록 합니다.
생검조직(Punch biopsy)
천자한 조직의 수분을 제거하고 거즈나 여과지에 10초 정도 올려놓은 후, 그대로 포르말린에 고정합니다. 조직이 작으므로 건조되지 않도록 주의합니다.

